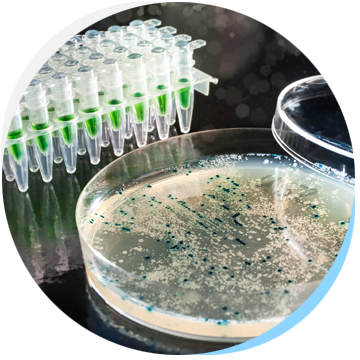

困擾家庭水質的四大問題有:泥沙雜質、硬水水垢、氯和有機汙染、細菌病毒
羅布森所提供的全屋式淨水系統,可幫助您全面處理水中的問題。
泥沙、雜質

硬水、水垢

餘氯、有機汙染

細菌、病毒
全屋空氣淨化系統包含:除濕防螨、濾菌除臭、新風交換 Honeywell 室內優質空氣處理系統,讓您享受全屋清新、乾爽的好空氣

全屋式智慧感應除濕機


中央電子式空氣清淨機


CO2監控全熱交換新風機

Copyright © 2017 寬碩實業有限公司. All rights reserved. Terms of Use | Privacy Policy














